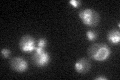
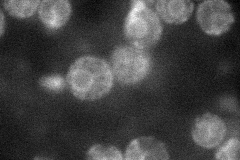
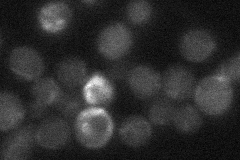

View description
Protein required for normal mitochondrial morphology, has similarity to hemolysins
Localization:
Intensity:
Fold change:
Significance:
-
C’ GFP library in SD
vacuole membrane36.72 -
N' NOP1pr-GFP in SD
ER47.7164 -
N' TEF2pr-mCherry in SD

ER15.0022 -
N' NATIVEpr-GFP in SD
below threshold19.5977 -
N' TEF2pr-VC and Cyto-VN in SD

below threshold23.0616 -
C’ GFP library in SD+DTT

vacuole membrane32.080.87No -
C’ GFP library in SD+H2O2

vacuole membrane34.80.94No -
C’ GFP library in Starvation Media

vacuole membrane42.81.16No -
C’ GFP library on the background of Pup2-DaMP

vacuole membrane -
C’ GFP library on the background of CCT mutant

vacuole membrane29.05030.790958No
